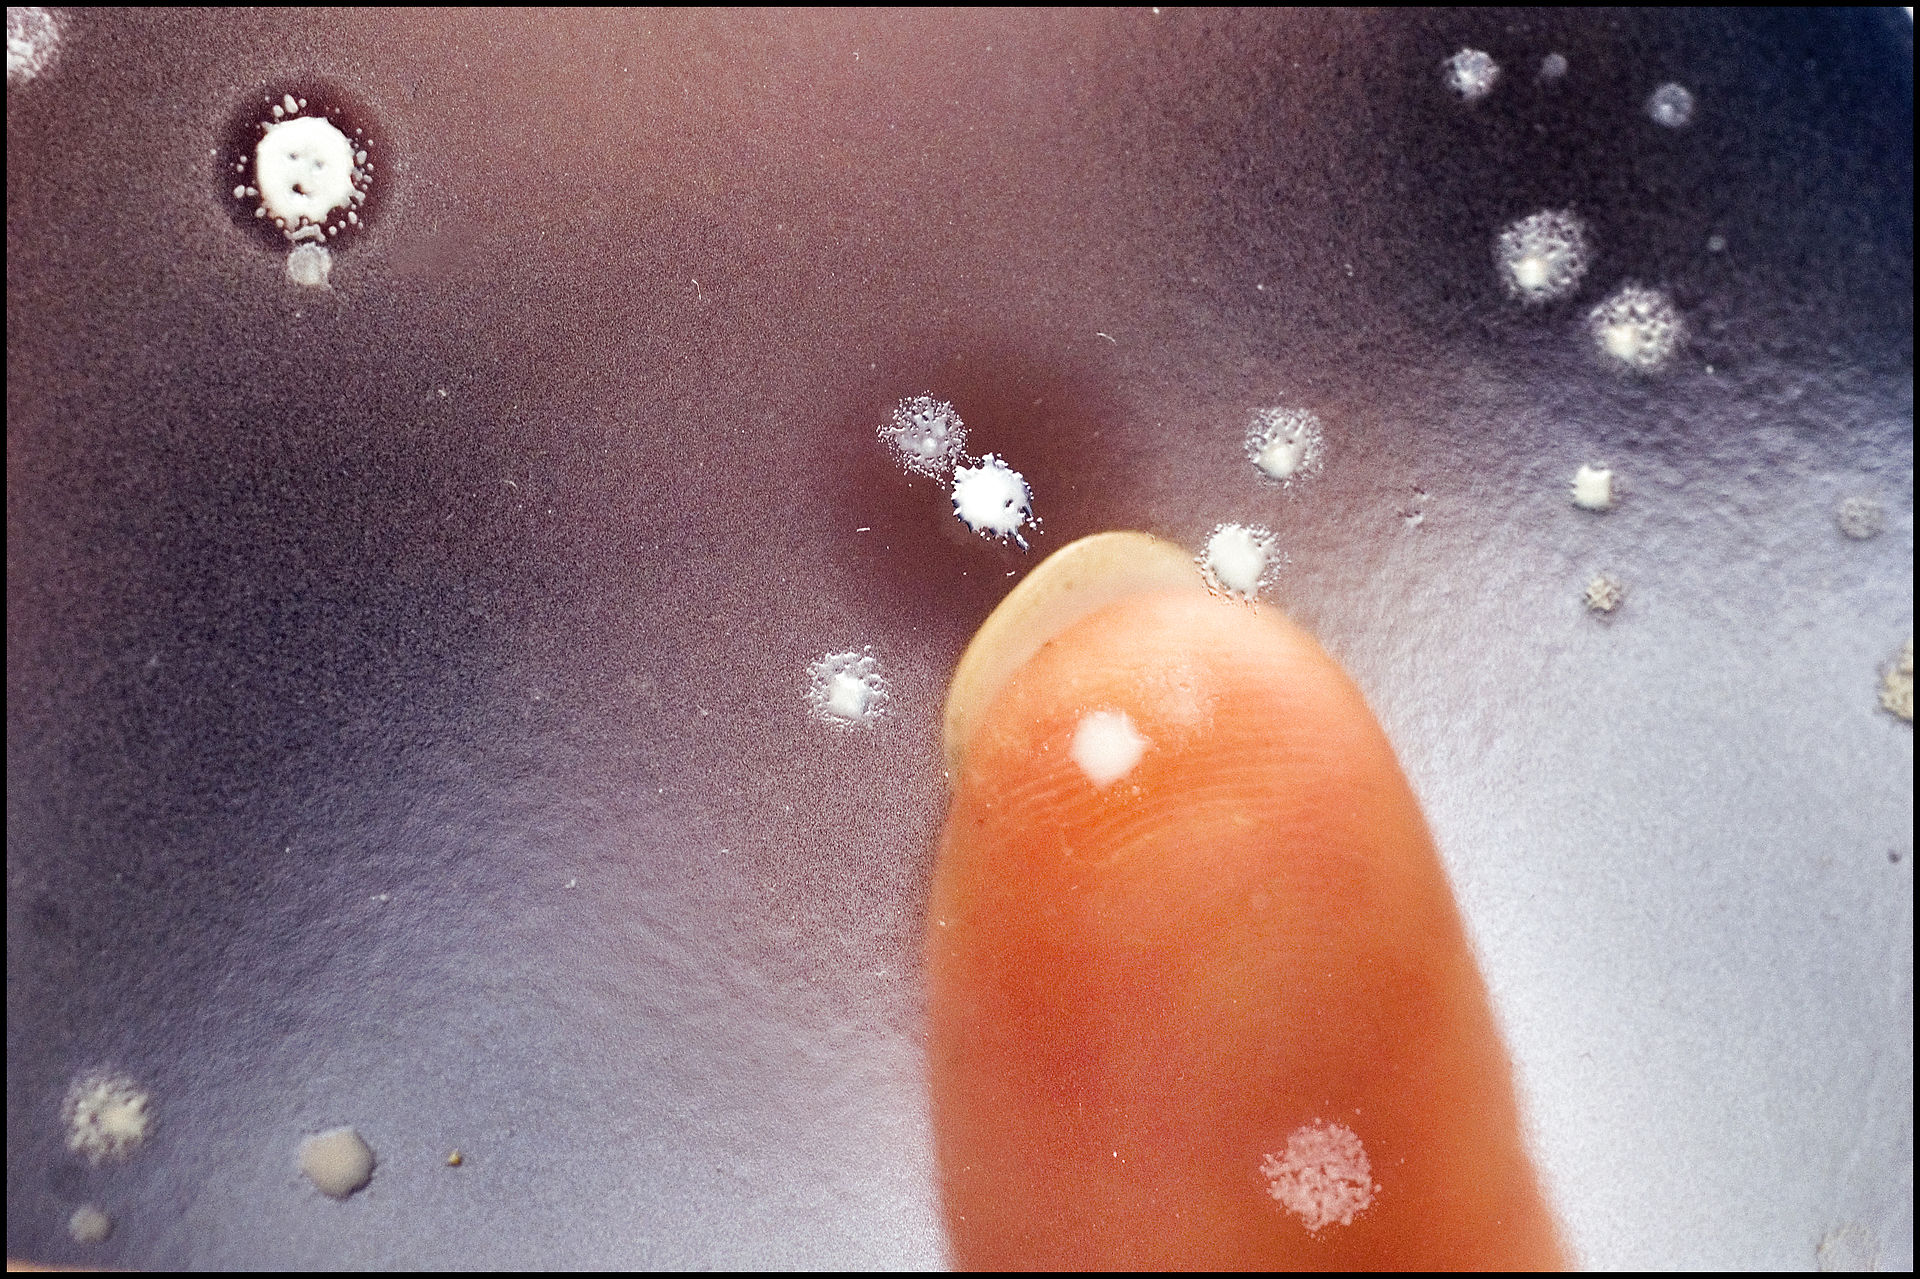

Nyhedsanalysen
En resistent dræber
En resistent dræber
Her er lidt til hypokonderne: Har du hørt om candida auris? Nej? Nå, men det er bare en vildt farlig svampebakterie, der ubemærket har spredt sig verden over. Forleden blev en mand indlagt med bakterien i New York. Han døde, men det gjorde bakterien ikke. Den var så massivt til stede i mandens lejlighed, at myndighederne måtte have en specialenhed ud og gøre rent og rive noget af loftet ned og brække gulvbrædder op for at få bugt med den. Åh ja, og forresten: Den er resistent overfor konventionel svampedræbende medicin. God tirsdag!
Galathea 3, togtben 5. Roseobacterbakterier. Atalnterhavet ud for Vestafrika.
…
